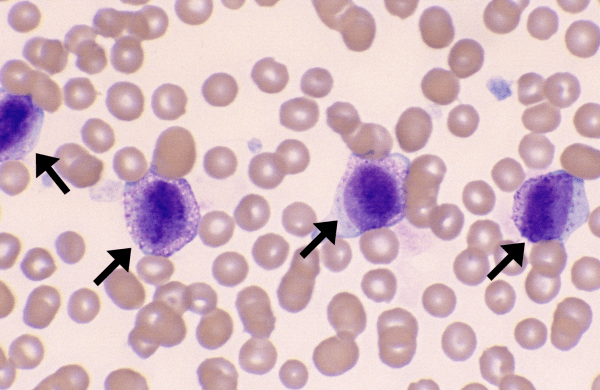

Mast Cells
Morphology: leukocyte with a large round nucleus and numerous dark purple or blue cytoplasmic granules. Usually seen at the feathered edge of blood smear. Considerable variation in appearance of mast… Read more Mast Cells →
Morphology: leukocyte with a large round nucleus and numerous dark purple or blue cytoplasmic granules. Usually seen at the feathered edge of blood smear. Considerable variation in appearance of mast… Read more Mast Cells →